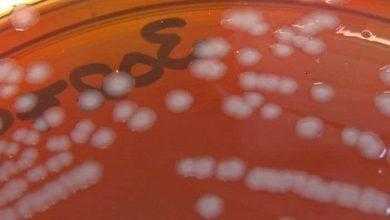
من الهلع في الأوساط الطبية بعد الكشف عن مصاب بالسيلان

لقاح جديد للحماية من عدوى "الهربس التناسلي" يُظهر نتائج واعدة في الفئران
طور فريق من الباحثين من كلية بيرلمان للطب-جامعة بنسلفانيا لقاحًا جديدًا يُساهم في الحماية من عدوى فيروس الهربس من النوع الثاني (HSV-2)؛ أو ما يُطلق عليه “الهربس التناسلي” .
وأكد الباحثون أن اللقاح الجديد قد أنتج مستويات مرتفعة جدًا من التحصين ضد العدوى، وذلك في اختبارات الفعالية على الفئران والخنازير الغينية.
كما أشاروا في دراستهم_التي نُشرت في مجلة Science Immunology_إلى أن المناعة الناتجة عن اللقاح الجديد تُعد من أقوى أنواع المناعة المعروفة ضد عدوى الهربس التناسلي.

شملت الدراسة حقن اللقاح في 64 من فئران التجارب السليمة، ثم تم تعريضها لعدوى الهربس التناسلي ومتابعة النشاط الفيروسي على مدار 28 يومًا.
وبعد مرور تلك الفترة، وجد الباحثون أن 63 فأرًا قد اكتسبوا مناعة تعقيمية ضد الفيروس؛ بمعنى أنه لم يُصابوا بالعدوى من الأساس.
بينما تمكن الفيروس من إحداث العدوى الكامنة في الفأر الأخير، ولكنها ظلت “نائمة” ولم تظهر أي أعراض للعدوى التناسلية عليه.
وقد تضمنت التجارب أيضًا 10 من الخنازير الغينية، والتي تستجيب لعدوى الهربس التناسلي بشكل يُشبه_إلى حد كبير_الاستجابة المناعية في البشر.
وبالمثل، لم تحدث العدوى في 8 من الخنازير الغينية، بينما أصيب اثنتان بالهربس التناسلي دون ظهور أي أعراض سريرية.
أي أن تحاليل الإصابة بالفيروس كانت إيجابية، ولكنها غير مصحوبة بأعراض ولا يمكنها الانتقال إلى خنزير آخر غير مصاب.
يقول البروفيسور هارفي فريدمان_قائد الفريق البحثي: “إننا نشعر بالفخر الشديد بعد مشاهدة نتائج اللقاح على النماذج الحيوانية”.
“نأمل أن تتطور تجاربنا إلى البشر قريبًا، ولكن هذا لن يحدث قبل إجراء المزيد من الدراسات على حيوانات التجارب”.
-
دراسة: الصدفية ترتبط بالضعف الجنسي
-
دراسة: الهربس يرتبط بنصف حالات الزهايمر على مستوى العالم
-
دراسة حديثة تنصح باستخدام لقاحات فيروس الورم الحليمي للوقاية من سرطان عنق الرحم
يعمل اللقاح الجديد ضد الهربس التناسلي عن طريق تحفيز 3 أنواع من الأجسام المضادة: الأول يمنع الفيروس من اختراق الخلايا، والاثنان الآخران يسلبانه القدرة على تثبيط الجهاز المناعي للكائن المصاب.
وهذا النهج يختلف كثيرًا عن باقي اللقاحات المضادة للهربس، والتي غالبًا ما كانت تكتفي بمنع الفيروس من اختراق الخلايا فقط.
يُذكر أن عدوى فيروس الهربس من النوع الثاني (الهربس التناسلي) هي أكثر الأمراض المنقولة جنسيًا حول العالم.
حيث تُشير الاستطلاعات إلى أن حوالي 11% من سكان العالم بين 14-59 عامًا مصابون بالفعل بالهربس التناسلي.
ويتسبب الهربس التناسلي في حدوث تقرحات مؤلمة على المناطق التناسلية في كل من الذكر والأنثى، والتي يمكن أن تنتشر إلى أجزاء أخرى من الجسم.
وتزيد عدوى الهربس التناسلي من فرص الإصابة بفيروس الإيدز؛ كما قد تنتقل العدوى من الأم المصابة إلى الجنين أثناء عملية الولادة.
يقول فريدمان: “تكمن خطورة الهربس التناسلي دون غيره من أشكال العدوى الفيروسية في أنه قد يٌسبب خسائر نفسية وعاطفية بالغة”.
“فهو يؤثر بشكل بالغ على العلاقات الحميمية بين الشريكين، إضافة إلى الآلام الشديدة والخوف من انتقال العدوى”.
-
طالع في قسم الأدوية المزيد من المعلومات عن عقار زيثروماكس Zithromax (مضادات الميكروبات).

موضوع قيم جدا لكن لم تعرّفوا ما هو الهربس التناسلي
شكراً لكم
الهربس التناسلي هو مرض جلدي فيروسي تناسلي ينتقل عن طريق العلاقة الزوجية